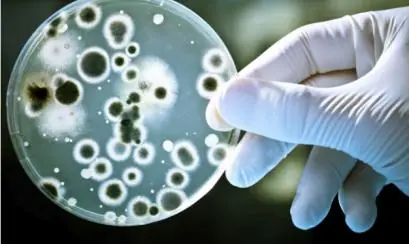
colombia:Bacterias de yuca ayudan a eliminar cianuro de río

radical64
Usuario (Colombia)

En el Luzhniki, donde Francia y Croacia disputarán la Copa Mundo, guarda el secreto de la peor tragedia del fútbol europeo El 20 de octubre de 1982 el Spartak de Moscú, recordado por ser el equipo del pueblo, no de los policías como el Dinamo ni el CSKA de Moscú de los militares soviéticos, jugaba contra el Haarlem de Holanda donde Ruud Gullit, una de las estrellas de la ‘Naranja Mecánica’ se había formado. Eran los dieciseisavos de la Copa de la UEFA, pero el duro frío de aquel día opacó el fútbol que 18.000 rusos estaban esperando. Cuando arrancó el partido estaban diez grados bajo cero y los hinchas fueron obligados a ubicarse en una sola tribuna del Estadio Central Lenin, hoy conocido como el Estadio de Luznhiki. El partido ya se estaba terminando y el Spartak ganaba 1- 0. Los aficionados, que no aguantaron más el clima, fueron saliendo del estadio pensando que el resultado se quedaba así. Pero un gol de Sergei Shvetsov despertó la euforia rusa. Todavía quedaba la mitad de los aficionados en las graderías, pero la otra mitad, saliendo por un único túnel habilitado, decidió volver para saber qué pasaba. “Ojalá nunca hubiera marcado ese gol”, dijo Shvetsov, que dio en una declaración años después. En la gradería, una mujer resbaló en las escaleras que conducían al túnel de salida. Después de 88 años se repetía la recordada escena filmada por el director ruso Serguéi Eisenstein las escaleras de Odesa. Cuando dos hombres intentaron ayudar a la mujer, el defensor del Spartak marcó el segundo tanto del encuentro. La gente que estaba afuera quiso devolverse guiada por el grito de gol de aquellos que se convirtieron en los testigos de una contradicción que rodea el fútbol: tanto la felicidad como la tragedia despertaba ese gol. link: https://www.youtube.com/watch?time_continue=4&v=c0VPfvcznqE El tenista ruso Andréi Chesnokov, quien llegó a estar en el top 10 del ATP, también estuvo en el estadio y se salvó de morir aplastado por la masa soviética después de agarrarse del congelado pasamanos de la escalera. “Algunos levantaban la mano, pedían ayuda. Pero no conseguían moverse. Logré agarrar a un muchacho, y desplazarlo unos metros en busca de una ambulancia, pero ya estaba muerto. Alejándome del estadio, vi que los cadáveres eran centenares”. Más 300 personas murieron en la estampida, pero nadie en Rusia supo de la tragedia. Los soviéticos decidieron ocultar el hecho, y aunque quedó registrado en el Vechernyaya Moskva, uno de los periódicos más leídos en Moscú, solo hablaron de 10 muertos, y rápidamente el “accidente” pasó al olvido de los moscovitas. Sin embargo, otros medios internacionales fueron publicando nuevos números, hasta que el Kremlin reconoció que no había sido un puñado de gente, sino 66 personas aplastadas. Solo 7 años después se supo que el gobierno había mentido y fabricado información –no podían demostrar una inferioridad frente a los americanos en plena Guerra Fría, con quienes sostuvieron una carrera tecnológica durante décadas–, pero en 1989 un reportaje del periódico Sovestsky Sport reveló lo que sería la Tragedia de Luzhniki: por lo menos 350 personas habían muerto en la avalancha. Después de tantos años, en 2007 varios exjugadores tanto del Spartak como del Haarlem holandés decidieron jugar un partido amistoso para conmemorar a las víctimas de ese día. Hoy frente al estadio existe un monumento conmemorativo por los aficionados que murieron por un gol de su propio equipo, y aunque el gobierno ruso nunca reconoció los más de 300 muertos, los fantasmas de la Tragedia de Luzhniki también serán asistentes silenciosos en la final del Mundial entre Croacia y Francia.

Liberaron a una millonaria que comandaba una secta acusada de tener "esclavas sexuales" Clare Bronfman, la heredera de una conocida empresa de licores conocida como Seagram's, fue dejada en libertad este miércoles en EE.UU. tras pagar una fianza de U$S 100 millones, luego de ser arrestada horas antes junto a tres personas en el marco de la causa de la secta NXIVM. Las otras personas detenidas fueron identificadas como Kathy Russell, contable de la secta, Nancy Salzman, presidenta de la organización, y su hija Lauren Salzman. Hasta ahora seis personas han sido acusadas como parte de la investigación, incluidos el líder del grupo, Keith Raniere, de 57 años, y la actriz de la serie televisiva "Smallville", Allison Mack, de 35, según informó la BBC. Raniere fue acusado, el pasado 13 de abril, formalmente en un tribunal de Nueva York por tráfico sexual, de conspirar para tráfico sexual y para obligar a trabajo forzado, por los que enfrenta un mínimo de 15 años de prisión y un máximo de cadena perpetua. La actriz Allison Mack (conocida por su papel de Chloe en la serie Smallville) reclutaba mujeres para la secta sexual (Clarín) Según la justicia, Bronfman estuvo involucrada en el robo de identidad de al menos dos mujeres, incluida una pareja sexual de Raniere que ya falleció. En este sentido, los seis están acusados de conspiración para cometer crimen organizado, concretamente, de intentar obtener dinero de forma ilegal o a través de la extorsión, según publicó la BBC. Podrían enfrentar hasta 20 años de cárcel, más un máximo adicional de 15 años por conspiración para cometer robo de identidad.

Grecia: La lección que todo el mundo debería aprender De acuerdo con lo que nos dicen los medios de comunicación, la actual crisis económica en Grecia se debe al gasto excesivo del gobierno, que ha llevado al país a la quiebra. Este es el discurso oficial, pero sin embargo, es una gran mentira. En realidad, son los bancos los que han destruído a Grecia, permitiendo que los oligarcas y las corporaciones internacionales se beneficien de ello. Lo estamos viendo repetido, una y otra vez, en todos los grandes medios de comunicación, como un discurso repetitivo destinado a lavarle el cerebro a la población “El gobierno griego gastó demasiado dinero y se fue a la quiebra; los generosos bancos les prestaron dinero, pero Grecia todavía no pueden pagar las cuentas, ya que han administrado mal el dinero que se les ha dado”. Es algo que suena bastante razonable y que por lo visto, mucha gente se ha creído. Pero es una inmensa mentira. Y no solo para Grecia, sino para otros países europeos como España, Portugal, Italia e Irlanda que también están experimentando diversos grados de austeridad. Esta misma mentira, ha sido utilizada por los bancos y las grandes empresas para explotar muchos países de América Latina, Asia y África durante muchas décadas. La verdad es que Grecia no quebró por sí sola. La han hecho quebrar. En resumen, los bancos destrozaron al gobierno griego y deliberadamente lo empujaron a contraer una deuda insostenible, de manera que los oligarcas y las corporaciones internacionales pudieran beneficiarse del caos y la miseria. Si usted es fan de las películas de la mafia, ya sabe cómo la mafia consigue apoderarse de cualquier negocio; por ejemplo, de un restaurante. ¿Cómo lo hace la mafia? En primer lugar, hacen algo para interrumpir o perjudicar el negocio, como por ejemplo, cometer un asesinato en el restaurante para perjudicar su imagen o provocar un incendio. Cuando el negocio comienza a sufrir las consecuencias, aparece el padrino y generosamente ofrece algo de dinero al propietario, como “muestra de amistad”. A cambio, uno de sus lugartenientes se hace cargo de la contabilidad del restaurante, otro de los suyos se puso a cargo de la contratación, y así sucesivamente, se va apoderando de la gestión completa del negocio. No hace falta decir que para el propietario, eso significa entrar en una espiral creciente de miseria, que pronto le llevará a la ruina…si tiene la suerte de seguir vivo, claro. Ahora, veamos como se aplica este principio mafioso a la financiación internacional, en cuatro etapas ETAPA 1 La primera y principal razón por la que Grecia se metió en problemas, fue la “gran crisis financiera” de 2008, que en realidad fue una creación de Wall Street y de los banqueros internacionales. Recordemos como sucedió todo: a los bancos se les ocurrió la “idea genial” de ofrecer hipotecas de alto riesgo a cualquier tipo de cliente, fuera quien fuera. A continuación, empaquetaron todas estas bombas de relojería financieras y las vendieron como “valores respaldados por hipotecas” con un beneficio enorme a varias entidades financieras en países de todo el mundo. Los que facilitaron en gran medida esta práctica delictiva, fueron los miembros de otra rama del sistema bancario, el grupo de agencias de calificación, como por ejemplo Standard & Poor’s, Fitch y Moody, que dieron calificaciones estelares a éstos productos financieros destinados a quebrar. Entonces, políticos sin escrúpulos como Tony Blair, fueron pagados por los grandes bancos para vender estos títulos peligrosos a fondos de pensiones, municipios y países de todo Europa. Los bancos y los gurús de Wall Street ganaron cientos de miles de millones de dólares siguiendo este esquema de negocio. Pero esta solo fue la Etapa 1 de su enorme estafa. ¡Había mucho más beneficio que hacer en las siguientes tres etapas! ETAPA 2 Fue en esta etapa cuando las bombas de relojería financieras estallaron. Los bancos comerciales y de inversión de todo el mundo comenzaron a derrumbarse en cuestión de semanas. Los gobiernos a nivel local y regional vieron sus inversiones y activos evaporarse. Fue un caos generalizado en todas partes. Buitres como Goldman Sachs y otros grandes bancos se beneficiaron enormemente de tres maneras: ·Una: podían comprar otros bancos como Lehman Brothers y Washington Mutual por céntimos de dólar. ·Dos: De forma mucho más cruel, Goldman Sachs y personajes poderosos con información privilegiada como John Paulson (que recientemente donó 400 millones de dólares a la Universidad de Harvard) apostaron previamente a que estos valores estallarían. Paulson ganó miles de millones, y los medios de comunicación, encima, celebraron su perspicacia. Algo realmente indignante. Para hacer una analogía, es como si los terroristas que atentaron contra el World Trade Center hubieran apostado a que las torres caerían el día antes y hubieran ganado millones con ello. Y que encima los medios, los llamaran “perspicaces”. ·Tres: en tercer lugar, y para restregar sal en la herida, ¡los grandes bancos exigieron un rescate a los propios ciudadanos cuyas vidas los banqueros habían arruinado! ¡Y lo hicieron y la gente tragó! Por ejemplo, en los EEUU, los banqueros consiguieron cientos de miles de millones de dólares de los contribuyentes y billones del Banco de la Reserva Federal, que en el fondo no es nada más que una organización privada de banqueros. (no hace falta decir lo que sucedió en España con entidades como Bankia) En Grecia, los bancos nacionales consiguieron más de 30 millones de dólares de rescate del pueblo griego. Es decir, ese Gobierno griego supuestamente irresponsable, tuvo que rescatar a los banqueros. ETAPA 3 La tercera etapa es cuando los bancos obligan al gobierno a aceptar enormes deudas. Si utilizamos una metáfora del mundo de la biología, imaginemos a un virus o una bacteria. Todos ellos tienen estrategias únicas para debilitar el sistema inmune del huésped. Una de las técnicas utilizadas por los banqueros internacionales parasitarios, consiste en rebajar los bonos de un país. Y eso es exactamente lo que hicieron los banqueros, a partir de finales de 2009. Esto hace que, inmediatamente, los tipos de interés (“rendimientos”) de los bonos suban, por lo que es cada vez es más caro para el país pedir dinero prestado o incluso pagar los intereses de los bonos existentes. Desde 2009 hasta mediados de 2010, los rendimientos de los bonos griegos a 10 años casi se triplicaron. Este asalto financiero cruel arrodilló por completo al gobierno griego y los banqueros consiguieron su primer acuerdo sobre la deuda, por la friolera de 110.000 millones de euros. Los bancos también controlan la política de las naciones. En 2011, cuando el primer ministro griego se negó a aceptar un segundo rescate masivo, los bancos le obligaron a dimitir y de inmediato lo reemplazaron por el Vice Presidente del BCE (el Banco Central Europeo). No necesitaron elecciones. La democracia es una ilusión controlada por esta gente. ¿Qué hizo el nuevo primer ministro? Obedecer las instrucciones que le dieron los banqueros sin rechistar. (Por cierto, al día siguiente, sucedió exactamente lo mismo en Italia, donde el primer ministro renunció, sólo para ser reemplazado por un títere de la banca internacional. Diez días más tarde, España vivió unas elecciones avanzadas donde una marioneta de la banca ganó las elecciones). Como vemos, los titiriteros vivieron una gran mes en noviembre de 2011. Pocos meses más tarde, en 2012, se utilizó la misma manipulación del mercado de bonos, cuando los banqueros elevaron los rendimientos de los bonos griegos a 50%. Este terrorismo financiero inmediato tuvo el efecto deseado: el parlamento griego acordó un segundo rescate masivo, incluso más grande que el primero. Llegados a este punto, se produce algo que la mayoría de la gente no entiende. Los préstamos no son sólo los préstamos simples, como los que se obtienen de una tarjeta de crédito o de un banco. Se trata de préstamos que vienen con condiciones muy especiales adjuntas, que exigen la privatización de los activos de un país. Si usted ha visto El Padrino III, recuerde a Hyman Roth, el inversor que fue a saquear Cuba con sus amigos. Reemplace a Hyman Roth por Goldman Sachs, el FMI (Fondo Monetario Internacional) o el BCE, y tendrá lo mismo. A esta etapa la llaman “Reformas estructurales”. La violación y la humillación de una nación comienza con el nombre de “austeridad” o de “reformas estructurales”. Debido al nivel de endeudamiento a la que fue sometida, Grecia ha tenido que vender muchos de sus activos rentables a oligarcas y corporaciones internacionales. Las privatizaciones han sido despiadadas, y en ellas se incluye cualquier cosa que sea rentable. En Grecia, las privatizaciones incluyen el agua, la electricidad, las oficinas de correos, los servicios aeroportuarios, los bancos nacionales, las telecomunicaciones, las autoridades portuarias (que son enormes en un país que es líder mundial en el transporte marítimo), etc. Por supuesto, los banqueros, especialistas en el arte de manipular, siempre exigen la inmediata privatización de todos los medios de comunicación, lo que significa que pueden inundar el país con propaganda todos los días y a todas horas sin oposición y decirle a la población que “ha abusado”, “que ha vivido por encima de sus posibilidades” y “que es corrupta” y que en cambio, los generosos banqueros que prestan su dinero, son los salvadores de la situación; además, se puede inocular en la población la idea de que vivir en la esclavitud de la austeridad es mucho mejor que la alternativa. Por si eso fuera poco, los tiránicos banqueros también llegan a dictar hasta la última línea de los presupuestos del gobierno, hasta el detalle más nimio. No existe este nivel de control exhaustivo en ningún otro tipo de relación entre acreedor y deudor. Así pues, llegados a este punto, ¿qué pasa tras la privatización completa del país y el despotismo explícito de los banqueros? Por supuesto, que los ingresos del gobierno caen acusadamente y que la deuda aumenta aún más. ¿Cómo se puede “arreglar” esta situación? Por supuesto, ¡recortando el gasto! Despedir a los trabajadores públicos, recortar el salario mínimo, recortar las pensiones, cortar los servicios públicos y aumentar los impuestos a las cosas que afectan al 99% pero nunca al 1% más privilegiado. Por ejemplo, las pensiones se han reducido a la mitad y el IVA ha subido a más del 20%. Todas estas medidas han llevado a Grecia a una calamidad financiera que es peor que la Gran Depresión de los EEUU en la década de 1930. Hace falta ser una clase especial de psicópata y criminal, para llevar a un país entero, a través de la austeridad, hacia el holocausto económico. Si cada persona en Grecia hubiera sabido la verdad sobre la austeridad, no habrían caído en esta trampa. Lo mismo sirve para España, Italia, Portugal, Irlanda y otros países que sufren las medidas de austeridad. Lo más triste de todo, es que éstas no son estrategias únicas. Desde la Segunda Guerra Mundial, estas prácticas predatorias han sido utilizadas innumerables veces por el FMI y el Banco Mundial en América Latina, Asia y África. Esta es la esencia del Nuevo Orden Mundial: un mundo propiedad de un puñado de corporaciones y bancos; un mundo que está lleno de obedientes siervos endeudados y sin poder. Un golpe de estado a nivel mundial, para devolvernos a un nuevo tipo de Feudalismo Global. Hay una fórmula del Fondo Monetario Internacional que siempre se usa para apoderarse de cualquier nación: La fórmula consiste en imprimir dinero, sacado de la nada…el dinero se presta a un país, mucho más allá de su capacidad para devolver el préstamo, preferentemente a oligarcas corruptos. Se espera a que el país caiga en problemas financieros y a continuación, se llega a un acuerdo para transferir todos los activos de infraestructura valiosos de ese país a sus acreedores internacionales. Resultado: Ahora los oligarcas son los dueños de las carreteras, de los puentes, de las plantas de tratamiento de agua, los puertos, las playas y los monumentos nacionales y pueden cobrar a los ciudadanos por su uso y controlar todos los aspectos de sus propiedades. Y todo ello “legalmente” El mundo está gobernado por psicópatas sin escrúpulos, la peor ralea de criminales de la historia; la mayoría de gente se niega a creerlo, pero estos tipos disfrutan haciendo daño: provocar sufrimiento les produce auténtico placer, les hace sentir poderosos. Y tienen como esbirros y abnegados servidores, a una amplia colección de matones con traje y corbata (y ahora también sin corbata), ocupando los altos puestos de la política, con el objetivo de aplicar sus órdenes. Cualquier muestra de respeto o admiración hacia alguno de estos auténticos demonios, es reflejo de una profunda debilidad mental y de una insufrible indignidad como ser humano. ¿De verdad alguien es tan ingenuo como para creer que se puede luchar contra estos criminales de masas votando a un partido político o saliendo a la calle a pasear pancartas? ¿Cómo alguien en su sano juicio pretende luchar contra ellos respetando las leyes y procedimientos, que ellos mismos han escrito, para tenernos a todos sometidos? Lo más “maravilloso” de la execrable traición de Alexis Tsipras a su pueblo, es que le ha mostrado al mundo cuál es la auténtica realidad de la situación y cómo funcionan realmente las cosas. A partir de aquí, el que no lo vea es que es directamente un idiota…

Menuda pesadilla la vivida por un turista en una isla de Australia, que quedó literalmente 'acorralado' por un cocodrilo gigante durante dos semanas. Cada vez que intentaba coger el kayak con el que había llegado hasta allí, éste hacía amago de atacarle obligándole a dar marcha atrás en su plan de huida. Un cocodrilo gigante ha sido la peor pesadilla para un turista en Australia, que quedó literalmente 'acorralado' durante dos semanas en una isla de este país al no poder zafarse del animal. El hombre, conocido como Ryan, estaba practicando kayak en Australia, cuando llegó a una isla situada a cuatro kilómetros de la costa, según informa The Daily Mirror. Su intención era hacer una parada para descansar. Bendita la hora. Un cocodrilo gigante apareció de repente para impedirle salir a tierra firme. Cada vez que el hombre intentaba coger el kayak para regresar a su punto de partida, aparecía el tremendo animal mostrando sus terroríficos dientes y disuadiendo a Ryan de su plan de huida. El cocodrilo lo tenía vigilado. Finalmente, tal como relató al citado medio, el turista optó por permanecer en la isla sobreviviendo con los víveres que encontraba por la zona. Por suerte, disponía de agua suficiente para aguantar la aventura (o pesadilla) de la que finalmente fue rescatado
Bacterias de yuca ayudan a eliminar cianuro de ríos contaminados por minería Investigadores colombianos han identificado hasta seis grupos de bacterias en las plantas de procesamiento de yuca, un tubérculo que crece en tierra tropical, capaces de eliminar el cianuro de los ríos contaminados por la minería aurífera. Cali (Colombia), 23 sep.- Investigadores colombianos han identificado hasta seis grupos de bacterias en las plantas de procesamiento de yuca, un tubérculo que crece en tierra tropical, capaces de eliminar el cianuro de los ríos contaminados por la minería aurífera. Esta alternativa es eficaz y más accesible que otros procedimientos químicos de limpieza de aguas residuales, pues los microorganismos que degradan el cianuro aparecen durante la fermentación del almidón de la yuca, también conocida como mandioca o casava, que sirve de materia prima para la panadería. "La idea de la aplicación biotecnológica es poder llevar este tipo de bacterias a sitios donde se hace minería, educar al minero para que haya un paso de descontaminación de sus aguas residuales" y evitar así que el cianuro llegue a los ríos, explicó a Colombia.inn, agencia operada por Efe, el bioquímico Joel Panay, líder del equipo de investigadores de la Universidad Icesi de Cali. Colombia, al igual que otros países de Suramérica, tiene importantes minas de oro y esta actividad está originando un gran impacto medioambiental por la contaminación de los caudales. La razón es que el cianuro se utiliza para separar el oro del resto de elementos extraídos en los ríos, por ser de los pocos reactivos químicos que disuelven el preciado metal en el agua, pero cuando esas aguas residuales donde se ha hecho la mezcla llegan a los ríos dejan una estela tóxica. El objetivo del equipo de Panay es dotar a los mineros de tanques con las bacterias extraídas en las plantas de procesamiento de yuca para que ellos mismos puedan contribuir a la descontaminación de las aguas residuales antes de que estas vayan a parar a los torrentes. Este desarrollo científico nació del proyecto "Biorremediación con bacterias degradadoras de contaminantes" que Panay presentó a sus alumnos en el laboratorio y que la estudiante Catalina Mosquera se apropió para aplicarla a la minería, en una zona donde esa actividad funciona como base de la economía de muchas comunidades.

Un ex miembro de la banda neoyorkina de origen iraní The Yellow Dogs mató a tres de sus antiguos compañeros de grupo y luego se suicidó. El músico usó un rifle semiautomático para disparar a los que un día fueron sus amigos en un apartamento situado en Buschwick, Brooklyn. La banda se había mudado a la ciudad de los rascacielos en 2011 procedente de Teherán (Irán). Al parecer, la relación entre los componentes del grupo con uno de ellos se había deteriorado tanto que terminaron por despedirle de la formación. Alegaban que este miembro, identificado como Raefe Ahkbar, les había robado dinero y equipamiento, algo con lo que el protagonista no estaba de acuerdo. De hecho, uno de los testigos de la zona oyó a un hombre gritar: "¿Por qué me habéis traído aquí para después despedirme?". Acto seguido, y según la información dada por la Rolling Stone, Ahkbar mató en el segundo piso del edificio al guitarrista Soroush Farazmand y posteriormente fue a la tercera planta para acabar con la vida del vocalista Ali Eskandarian y el batería Arash Farazmand. También hirió a Sasan Sadeghpourosko, que no era miembro del grupo. Un vecino asegura que llegó a escuchar hasta 45 disparos. Uno de ellos, presuntamente, sería el que terminaría con la vida del propio autor del crimen, que se había disparado en la cabeza en la azotea del inmueble, donde fue encontrado su cuerpo junto al rifle. The Yellow Dogs era una banda popular en la zona y había conseguido cierto éxito desde que en 2009 se estrenara el documental No One Knows About Persian Cats, que narra la historia de varios músicos que intentan grabar un disco, realizar un concierto y conseguir pasaportes que les permitirían abandonar Irán. Aquí podemos ver un extracto de New Century, la canción que aportaron al film. link: http://www.youtube.com/watch?v=UYjJLjxeVG0
Negociación climática internacional El 2013 será uno de los años más calurosos de la historia El año 2013 se perfila como uno de los más calurosos de la historia, según un informe de la Organización Meteorológica Mundial (OMM) hecho público ayer en la Conferencia contra el Cambio Climático (COP19 ), que se celebra de Varsovia. En el documento, la COP19(Cumbre sobre el Cambio Climático), inaugurada el lunes en Varsovia, revela que la temperatura media mundial entre enero y septiembre de 2013 ha sido aproximadamente medio punto superior a la media registrada entre 1961 y 1990. Asimismo, se indica que el aumento del nivel del mar hace que las poblaciones costeras sean más vulnerables a las tempestades, como se ha podido comprobar en Filipinas, cuya zona central ha quedado arrasada tras el paso del tifón Haiyán, que ha causado al menos 10 mil muertos. No obstante, la OMM reconoce que los desastres naturales están vinculados a muchos factores, no sólo el cambio climático. Al mismo tiempo las sequías, inundaciones y precipitaciones extremas confirman que el ciclo del agua también está sufriendo variaciones. Aunque la relación entre el cambio climático y la frecuencia de los ciclones tropicales es un asunto que sigue investigándose, señala la organización, sí es previsible que el calentamiento global haga que el impacto de estos fenómenos naturales sea más intenso La declaración provisional de la OMM vuelve a confirmar que el nivel del mar aumenta y de hecho en lo que va de año alcanzó un nuevo máximo histórico. Desde 1993 el nivel de los mares y océanos se ha incrementado una media de unos 3,2 milímetros por año. El nivel del mar seguirá aumentando debido al derretimiento de los casquetes polares y los glaciares, aseguran los expertos, ya que más del 90% del exceso de calor que se genera con los gases de efecto invernadero es absorbido por los océanos.

Científicos consiguen 'convertir' un cerebro femenino en masculino El cerebro de la mayoría de los animales desarrolla características específicamente femeninas y masculinas durante la fase prenatal. No obstante, un reciente estudio demuestra que el 'género' del cerebro puede ser más flexible de lo que se pensaba. Con el fin de comprender mejor cómo un cerebro desarrolla el género, un grupo de científicos estadounidenses ha investigado el desarrollo cerebral en ratas recién nacidas. Los resultados de su estudio han sido publicados por la revista 'Nature'. http://www.nature.com/neuro/journal/vaop/ncurrent/full/nn.3988.html En el experimento, los científicos inyectaron inhibidores de el ADN metiltransferasa en una región específica del cerebro de las ratas hembras, denominada área preóptica. En todas las especies estudiadas, incluidos los humanos, esta área juega un papel clave en determinar el comportamiento sexual masculino. Las inyecciones se realizaron en la primera semana después del nacimiento. Como resultado, el área preóptica en estos animales se transformó adoptando características estructurales de una rata macho. Asimismo, las ratas hembras empezaron a comportarse de manera diferente, mostrando un comportamiento sexual típico de ratas macho. Un resultado similar también se ha conseguido en ratones. "Físicamente, estos animales eras hembras, pero en su comportamiento reproductivo eran machos", ha contado Bridget Nugent, una de las investigadoras, en un comunicado de prensa de la Universidad de Maryland. "Fue fascinante ver esta transformación", ha agregado la científica.

se que ya puede estar posteado esta data pero lo importante es informar cosa que desde hace años aca en taringa va de mal en peor ¿Puede la superpoblación causar la destrucción de la raza humana? Los ratones tienen la respuesta Ya hemos visto anteriormente que con más de 7 mil millones de personas en el mundo, resulta complicado hacerse una idea de los recursos y de lo mal repartidos que están. Con una masa poblacional en continua expansión demográfica, no es de extrañar que los mensajes de alarma se sucedan preveiendo escenarios apocalípticos y derrotistas, lamentable puede que no estén equivocadas. Y es que todas las civilizaciones que han existido en la historia han terminado colapsando tarde o temprano. La única que aun no lo ha hecho es la civilización actual, gracias al uso de la tecnología, el conocimiento de la medicina y la higiene, el transporte y la globalización. Sin embargo, al ritmo de crecimiento que vamos y con el cambio climático en ciernes, el sistema de extracción de alimentos y recursos energéticos se volverá insostenible en un mundo superpoblado. ¿Puede la superpoblación ser el motivo de nuestra destrucción? Nada es seguro, pero el etólogo John B. Calhoun estuvo varias décadas estudiando los efectos adversos de una población descontrolada, utilizando para ello ratones de laboratorio. Para ello Calhoun creaba lo que él llamaba “universos”, pequeños mundos en miniatura en los que los ratones tenían toda la comida e infraestructuras que necesitarán para estar totalmente libres de depredadores, enfermedades y cambios climatológicos. La única limitación que existía era el espacio. El más famoso de los mundos que creó Calhoun, fue sin duda, el Universo 25; un mundo ideal construido en 1968 y que tras 4 años en funcionamiento presentó unos resultados tan asombrosos como perturbadores. El Universo 25 El Universo 25 fue un pequeño recinto cerrado de 2,5 m2 de superficie y 1,37 metros de altura, diseñado con el objetivo de ser el paraíso terrenal de los ratones de laboratorio. El lugar tenía todo el alimento, agua, material de nidificación y lugares para construir nidos ilimitados durante todo el experimento. Las condiciones de temperatura y humedad se mantuvieron ideales y el recinto se limpiaba a fondo cada cierto tiempo. En un inicio, el recinto se inauguró introduciendo 4 parejas de ratones perfectamente sanos, lo que sucedió en el experimento se describió en 5 fases. Fase A: días 1 al 104. Durante los primeros 104 días los ratones se sintieron agitados y alterados debido al nuevo entorno, pero una vez se familiarizaron, comenzaron a reproducirse. Fase B: días 105 al 315. También llamada fase de crecimiento rápido en un entorno ideal. La población de ratones se duplicaba cada 55 días; para el día 315, más de 600 ratones vivian en Universo 25, organizados en 14 grupos sociales con un macho dominante y roles sociales bien definidos para cada uno de los individuos. Fase C: días 316 al 560. Una vez que el grupo alcanzó la cifra de 615 individuos, la tasa de crecimiento se redujo y la población pasó a duplicarse cada 145 días. Los problemas de espacio comenzaban a ser evidentes ya que más de 300 machos competían constantemente por conquistar y mantener una parcela de territorio y poder reproducirse. Ante tal estrés, muchos machos comenzaron a abandonar el territorio, perdiendo el atractivo ante las hembras, lo que se tradujo en una bajada de la tasa de reproducción. Las hembras fértiles por su parte trataron de ocupar el rol abandonado de los machos para proteger los nidos, volviéndose más agresivas. Esta nuevo rol femenino afectó a las nuevas camadas de ratones, las cuales disfrutaron de un periodo de lactancia más corto, fueron abandonadas, atacadas y/o devoradas por sus propias madres. La sociedad estaba empezando a colapsar. La agresividad del grupo aumentó y se volvió un rasgo generalizado. A pesar de que había comida en abundancia en los extremos del recinto, los machos más débiles quedaron acorralados en el centro del hábitat, lejos de los comederos y de los recursos. Estos machos continuaron rindiéndose a la desidia y y la inactividad casi total, pero en ocasiones y de forma impredecible, estallaban en cólera y atacaban en masa a otros ratones. Calhoun, denominó a este grupo “la Cloaca del comportamiento”. Para el día 520, la población alcanzó los 2.200 ratones que vivían en un mundo anárquico, violento y casi sin sexo. A partir del día 560, ya no había más crecimiento: morían más ratones de los que nacían. Fase D: días 561 al 1471. Llegados a este punto, la violencia entre grupos estalló, y comenzó el canibalismo de las crías con bastante frecuencia. Un grupo de machos se atrincheró en una zona protegida dedicándose en exclusiva al cuidar su cuerpo acicalando su pelaje todo el día, mostrando una total apatía por cualquier otra actividad, sin pelear y sin mostrar el más mínimo interés por la hembras. Calhoun los bautizó como “los guapos” porque no tenían heridas ni cicatrices. La mayoría de las hembras que nacieron ya no se quedan embarazadas, ni tenían comportamientos maternales y de las pocas crías nacidas, muy pocas alcanzaban la edad adulta. Con este escenario, el día 600 nació el último ratón que se convirtió en adulto. El día 920, la tasa de nacimiento es cero. Llegados a este punto, la edad media de la población es de 776 días, 200 días más que la edad que marca la menopausia en los ratones. El fin. El día 1471 finalizaba el experimento. Sólo quedaban vivos 27 ratones, de los cuales 23 hembras y 4 machos. El más joven de todos, tenía 987 días edad, el equivalente a 90 años de vida humana. Colapso en la abundancia. Lo más llamativo del experimento es que en todo momento los ratones recursos de sobra, incluso en el máximo de población, nunca faltó agua, comida o lugares de nidificación. Sin embargo, la superpoblación destruyó la estructura social y mental de los ratones, empujándolos hacia comportamientos violentos y asociales. Según Calhoun, el colapso se produjo cuando los ratones dejaron de comportarse como ratones, algo que él denominó como “la primera muerte”. Aunque diversos ratones del Universo 25 fueron extraídos y recolocados en nuevos ambientes sanos, su comportamiento no cambió. Pero lo más sorprendente fue que cuando se introdujeron ratones nuevos y normales en edad de procrear en el Universo 25, no mostraron conductas reproductivas. 7 mil millones de humanos y aumentando. Ciertamente es muy aventurado parangonar el comportamiento de los ratones al de los humanos dada nuestra mayor complejidad social, y el desarrollo técnico y tecnológico que desarrollamos, pero estoy completamente seguro de que habrás identificado similitudes, que como poco invitan a la reflexión. ¿Qué nos deparará el futuro? No lo sabemos, pero en un Universo 25 como es la Tierra donde aun existen recursos para todos, existe hambre, conflicto, guerra y violencia. Tal vez los humanos hemos dejado ya de comportarnos como humanos.

francia convertira las teorias conspirativas en ilegales por decreto del gobierno El primer intento al respecto lo realizó en otoño pasado el primer ministro británico, David Cameron, anunciando públicamente en dos ocasiones distintas, que las llamadas “teorías de la conspiración”, deberían ser consideradas como “extremistas” y equivaler a “terrorismo” y que por lo tanto deberían ser eliminadas de la sociedad por motivos de “seguridad nacional”. Ahora, Hollande trata de dar el primer paso firme en esa dirección. Para ello, Hollande ha equiparado las “teorías conspirativas” con el nazismo y está llamando a realizar regulaciones gubernamentales para prevenir cualquier uso compartido o publicación de cualquier punto de vista que se considere como “pensamiento peligroso” para el Estado. En concreto, Hollande está citando “El antisemitismo”, y también todo aquello que pueda inspirar “actos de terrorismo”, todo ello a raíz de los ataques a la revista Charlie Hebdo. De momento, los esfuerzos se centrarán en presuntas actividades “islamistas radicales”, no obstante, las definiciones de “teorías conspirativas”, “extremismo” o “amenaza a la seguridad nacional” son tan vagas que pueden llegar a abarcar cualquier opinión que resulte incómoda para los respectivos gobiernos. Parece que las élites políticas están decididas a eliminar cualquier alternativa de análisis y de opinión que se salga del redil, calificándola de “extremista” ¿Aún crees que vivimos en países democráticos?